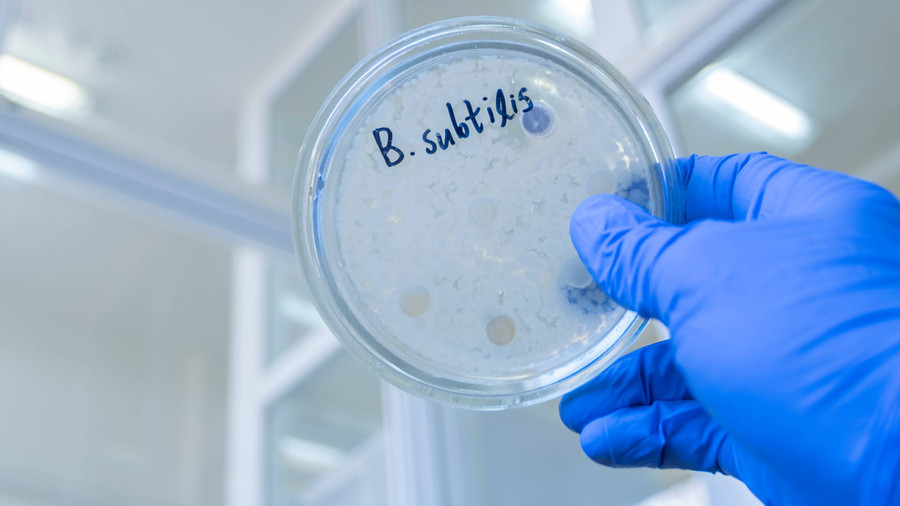
Ternyata Bakteri Juga Punya Ingatan - kumparan.com

#30 tag 24jam

Sertijab Menteri UMKM, Teten: Saya Yakin Pak Maman Bisa Lebih Ngebut
Menteri Koperasi dan UKM Teten Masduki serah terima jabatan kepada Maman Abdurrahman. [294] url asal
#sertijab-menteri-umkm #teten-masduki #maman-abdurrahman #koperasi #umkm #pelantikan-kabinet #menteri-koperasi #prabowo #oleh-oleh #memori-jabatan #ukm-teten #sertijab-menteri #gedung-smesco #jokowi #transisi #pel
(detikFinance - Ekonomi dan Bisnis) 21/10/24 16:46
v/16792129/

Cerita Teten Masduki Berkemas dari Rumah Dinas-Rencana Usai Lengser
Menteri Koperasi dan UKM Teten Masduki buka-bukaan tentang rencananya setelah selesai masa jabatan 20 Oktober nanti. [592] url asal
#teten-masduki #menteri-koperasi-ukm #menkop-ukm #widodo #pos-bloc #penerus #ukm-teten-masduki #kesehatan #restrukturisasi #menteri-penerus #memori-jabatan #sri-mulyani #pemerintahan-era-presiden-teprilih-prabowo
(detikFinance - Market Research) 17/10/24 19:54
v/16615809/

Disebut Jokowi Sudah Tembus Rp 58,41 T, Ini Daftar Lengkap Investasi di IKN
Total investasi di IKN mencapai Rp 58,41 triliun dari groundbreaking tahap 1-8. Proyek mencakup berbagai sektor untuk masa depan Nusantara. [453] url asal
#investasi-ikn #jokowi #otorita-ibu-kota-nusantara #groundbreaking #unggahan-oikn #oikn #beranda-nusantara #komando-distrik-militer #pln #jokowi-sudah-tembus-rp-58 #41-t #tulis #memorial-park #showroom-electric-veh
(detikFinance - Sosok) 10/10/24 18:00
v/16260603/

Nyoman Nuarta Ungkap Makna Memorial Park di IKN
Kementerian Pekerjaan Umum dan Perumahan Rakyat (PUPR) terus mempercepat pembangunan taman makam pahlawan (memorial park) di ibu kota Nusantara (IKN). [365] url asal
#ikn #ibu-kota-nusantara #nyoman-nuarta #memorial-park-ikn
(detikFinance - Perencanaan Keuangan) 11/08/24 17:30
v/14192760/

Samsung Produksi Memori LPDDR5X Tertipis, Bisa Bikin HP Lebih Dingin
Chip memori LPDDR5X baru dari Samsung lebih tipis dibandingkan produk lain sejenisnya sehingga bisa meningkatkan aliran udara di dalam smartphone. Halaman all [394] url asal
#memori #samsung #lpddr5x #chip
(Kompas.com) 07/08/24 14:02
v/13654450/

Samsung Luncurkan MicroSD Pro Plus dan Evo Plus, Kapasitas hingga 1 TB
Duo kartu memori microSD terbaru Samsung menggunakan memori V-NAND generasi ke-8. Selain berkapasitas besar, kecepatannya juga tinggi. Halaman all [599] url asal
#kartu-memori #microsd #samsung #samsung-pro-plus #samsung-evo-plus
(Kompas.com) 01/08/24 13:02
v/12867744/
Ternyata Bakteri Juga Punya Ingatan - kumparan.com
Bakteri baik seperti Bacillus subtilis memiliki kemampuan mengingat yang luar biasa, yang membantu mengingat interaksi masa lalu dengan inangnya. [301] url asal
#bakteri #memori #riset #studi
(Kumparan.com - Tekno & Sains) 28/07/24 16:57
v/12429582/

Pengertian Micro SD sebagai Salah Satu Hardware Penyimpanan - kumparan.com
Micro SD termasuk salah satu jenis hardware yang digunakan untuk menyimpan memori file. [310] url asal
(Kumparan.com) 15/07/24 19:14
v/10871832/

Review SanDisk Desk Drive 8 TB, SSD Premium Bisa Colok Langsung ke Windows - Mac - kumparan.com
Seperti apa perorma SSD 8 TB? Copy/paste 'sekejap mata' hingga backup data ratusan GB dengan cepat. [510] url asal
(Kumparan.com - Tekno & Sains) 09/07/24 08:15
v/10166324/

Memori GDDR7 Siap Dongkrak Performa Game hingga 30 Persen
Calon memori baru GDDR7 untuk kartu grafis disebut memiliki bandwith jauh lebih tinggi dibanding jenis terdahulu sehingga ikut meningkatkan frame rate Halaman all [378] url asal
(Kompas.com) 06/07/24 18:19
v/9877655/


